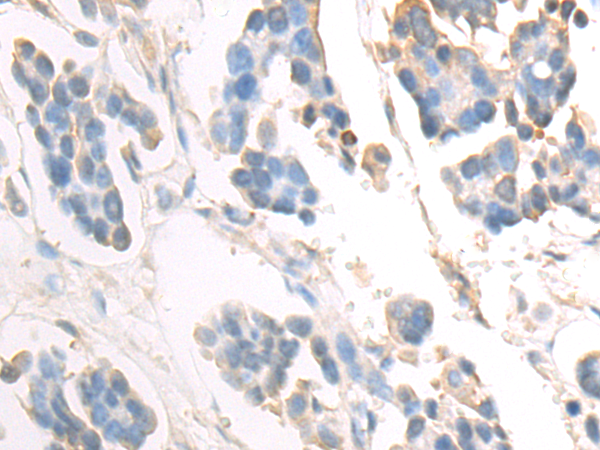
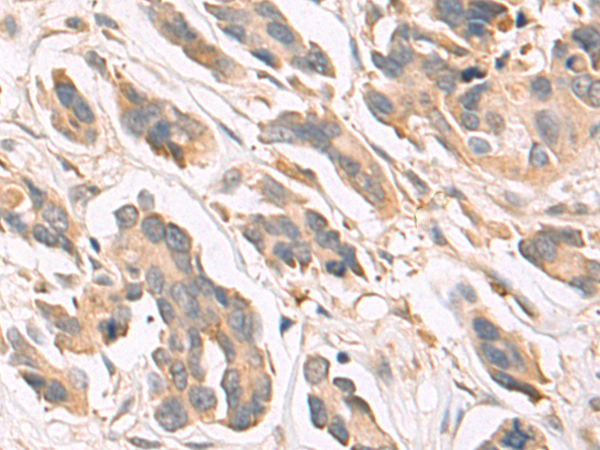

-
分类: 科研抗体货号: P07498别名: NT4, NT5, NT-4, NT-5, NTF5, GLC10, GLC1O, NT-4/5应用: WB,IHC反应种属: Human, Mouse, Rat
-
分类: 科研抗体货号: P07497别名: ANON2; BULN2应用: WB,IHC反应种属: Human, Mouse, Rat
-
分类: 科研抗体货号: P07515别名: JPDI, MTHr, ERdj5, PDIA19应用: IHC反应种属: Human
-
分类: 科研抗体货号: P07496别名: NRF2; HEBP1; Nrf-2; IMDDHH应用: WB,IHC反应种属: Human, Mouse, Rat
-
分类: 科研抗体货号: P07532别名: PCB应用: WB反应种属: Human, Mouse, Rat
-
分类: 科研抗体货号: P07514别名: DJ11, DJC7, TPR2, TTC2应用: WB,IHC反应种属: Human, Mouse
-
分类: 科研抗体货号: P07495别名: NRF1; TCF11; LCR-F1应用: WB,IHC反应种属: Human, Mouse
-
分类: 科研抗体货号: P07531别名: CCM3, TFAR15应用: WB,IHC反应种属: Human, Mouse, Rat
-
分类: 科研抗体货号: P07513别名: P58, HP58, ERdj6, PRKRI, P58IPK应用: IHC反应种属: Human, Mouse, Rat
-
分类: 科研抗体货号: P07494别名: PYY4应用: WB反应种属: Human, Mouse, Rat

鄂公网安备42018502007531号
鄂公网安备42018502007531号

